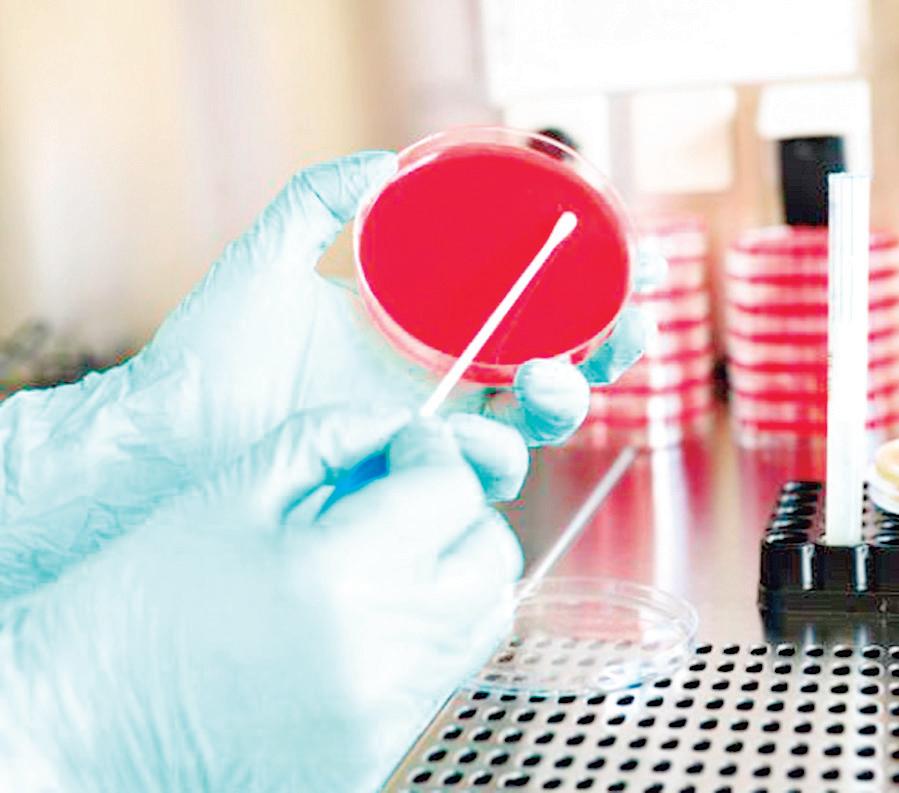

CON OBRAS DE IMPACTO SOCIAL, EDUARDO RAMÍREZ

![]()

Ganaderos anuncian liberación de millones de moscas estériles para combatir la propagación de larvas en el sureste del país. Desde Tapachula, Chiapas comenzará a dispersarse informó el secretario de Agricultura y Desarrollo Rural en México, Julio Berdegué Sacristán, durante una visita a Coatzacoalcos. PASE A LA 3


Avanza construcción de tren MéxicoPachuca
Presidenta Claudia Sheinbaum supervisa obra que conectará a las dos ciudades en un tiempo de recorrido de una hora 15 minutos en beneficio de 108 mil pasajeros al día. PASE A LA 12


Llama PC a revisar autos para evitar cortos circuitos
El titular de la dependencia, David Esponda Cruz, dijo que el mayor número de llamadas que reciben es por incendio en unidades motoras, pero también en viviendas del puerto. PASE A LA 2



80% del agua concesionada en Veracruz, a la agricultura
El uso doméstico representa una mínima parte frente a la demanda productiva. PASE A LA 4

Enciende alerta caída en remesas para familias pobres
Aunque a nivel nacional las remesas representan 3.5% del producto interno bruto (PIB), en algunas entidades la dependencia sobre esos recursos es significativamente mayor. PASE A LA 4

El titular de la dependencia, David Esponda Cruz, dijo que el mayor número de llamadas que reciben es por incendio en unidades motoras, pero también en viviendas del puerto.
ENRIQUE BURGOS
COATZACOALCOS, VER.
La dirección de Protección Civil en Coatzacoalcos exhortó a la ciudadanía a realizar el mantenimiento de sus vehículos de manera periódica a fin de evitar cortos circuitos.
ENRIQUE BURGOS
COATZACOALCOS, VER.
Un fuerte accidente se registró en el malecón de Coatzacoalcos, donde un conductor perdió el control de su vehículo al circular en exceso de velocidad.
El hecho se registró a las 11:00 de la mañana en malecón y Francisco Tellez de la colonia Playa Sol, justo donde se encuentra un edificio abandonado.
Fue el conductor de un Mazda blanco, con placas XYX 299C quien circu-
DE COATZACOALCOS
El titular de la dependencia, David Esponda Cruz, dijo que el mayor número de llamadas que reciben es por incendio en unidades motoras, pero también en viviendas del puerto.
Precisó que algunos de los autos al
momento del corto circuito están estacionados o en movimiento, o bien, otros salieron del taller.
“Hemos tenido casos de vehículos detenidos en la vía pública y en movimiento, eso es más constante de lo que creemos, lo importante es que los ciudadanos le den el mantenimiento correspondiente al vehículo, en cuanto detecten una falla, las computadoras famosas son indican que falla pueden tener nuestros vehículos, para evitar que tengamos incendios de nuestro carro”, comentó.
Explicó que las causan son por sobre calentamiento, por fuga de anticongelante, o bien por no darle mantenimiento.
Mientras que en el caso de las viviendas, los cortos circuitos son consecuencia del sobrecalentamiento de extensiones o multi contactos que están saturados. “Pero también en nuestra casa tenemos que estar pendiente, no sobrecargar las extensiones, poner sobrecargas en áreas que no están adecuadas, hacer revisiones constantes de nuestras instalaciones eléctricas”, finalizó.

laban de poniente a oriente sobre malecón y perdió el control por lo que se subió al camellón y colisionó contra una banca de concreto.
Debido al fuerte impacto, la banca quedó destrozada y tanto el chófer como la mujer que iban en el automóvil resultaron lesionados.
Al lugar acudieron paramédicos quienes brindaron los primeros auxilios y los trasladaron a un hospital. Hace dos semanas se registró otro percance pero a la altura de la colonia Pensiones, en esa ocasión fue una camioneta de redilas la que se impactó contra otra de estas bancas.
»REDACCIÓN
Xalapa, Ver.- La Unidad Canina K9 de la Secretaría de Seguridad Pública obtuvo el Primer Lugar Nacional por Excelencia en el Campeonato de Perros de Servicio Policial, celebrado en Ciudad Cuauhtémoc, Chihuahua. El binomio integrado por el policía Eduardo Guzmán Vitalez y el ejemplar Canelo alcanzó calificación de excelencia en ambas fases de la competencia: Obediencia (96/100) y Protección (96/100), superando a las corporaciones participantes en el marco del 25º aniversario de la Unidad Canina de la Dirección de Seguridad Pública y Vialidad Municipal. Este reconocimiento nacional refleja el alto nivel de preparación y disciplina del equipo veracruzano, fruto de un adiestramiento especializado y apegado al Protocolo de Actuación Policial para la Unidad Canina K9 y a la Ley Nacional sobre el Uso de la Fuerza, garantizando un servicio profesional y respetuoso de los derechos humanos.

»ENRIQUE BURGOS
Coatzacoalcos. Ver.- Una joven perdió la vida en el Hospital General de Minatitlán (HGM) luego de haber recibido un disparo en el abdomen en un asalto durante la madrugada de este domingo en la colonia Insurgentes Norte.
El atraco se habría presentado en el boulevard Instituto Tecnológico esquina Independencia.
De acuerdo con los datos recabados, la víctima y su acompañante, un varón, fueron interceptados por el delincuente quien tras exigirles sus pertenencias les disparo, lesionado a ambos.
Heridos de gravedad, fueron llevados en un vehículo al hospital, donde ingresaron poco después de la 1:00 de la mañana. A pesar de los esfuerzos médicos, la dama falleció horas más tarde debido a las lesiones internas.
Autoridades ministeriales tomaron conocimiento de los hechos e iniciaron las investigaciones correspondientes para dar con el responsable.



Ganaderos anuncian liberación de millones de moscas estériles para combatir la propagación de larvas en el sureste del país.
ENRIQUE BURGOS
COATZACOALCOS, VER.
Desde Tapachula, Chiapas comenzará a dispersarse la mosca estéril para combatir al Gusano Barrenador de Ganado (GBG) en el sureste de México.
Lo anterior lo informó el secretario de Agricultura y Desarrollo Rural en México, Julio Berdegué Sacristán, durante una visita a Coatzacoalcos.
REDACCIÓN
COATZACOALCOS, VER.
Como parte de las actividades previas al Festival del Mar 2025, que se celebrará del 15 al 17 de agosto, se llevó a cabo un emotivo encuentro artístico y cultural en Plaza Forum Coatzacoalcos, donde grupos locales y de la región ofrecieron un espectáculo lleno de color, tradición y talento.
El Gobierno del Estado, a través de las Secretarías de Turismo (Sectur) y de Cultura de Veracruz (SECVER), en coordinación con autoridades municipales, organizó esta jornada cuyo objetivo es fortalecer la identidad regional y promover la riqueza cultural del sur veracruzano.
Destacaron las presentaciones del Ballet Folklórico Nicté-Ha; el grupo de jaraneros Son de Aquí; la Banda Filarmónica de Minatitlán; el ballet Sinypoxi de Zaragoza; los jaraneros Chalada; y el grupo de danza folklórica Tizoc, entre otros colectivos que trabajan por preservar y difundir las expresiones culturales de la región.
La agenda previa al Festival del Mar 2025 continuará en distintas sedes de la región con talleres, presentaciones
Y es que dio detalles sobre una planta que producirá al insecto para noviembre y diciembre.
“Esa planta va a estar lista para noviembre o diciembre, para empezar a producir una mosca estéril, que se va a empezar a regar en toda la zona sur-sureste, para que combata a la mosca del gusano barrenador y la neutralice”, comentaron ganaderos que asistieron al encuentro.
Fue ese fin de semana que autoridades
federales, estales y ganaderos sostuvieron una reunión en Coatzacoalcos para fortalecer las medidas contra el GBG.
En el encuentro, se reiteró que tanto México como Estados Unidos están trabajando de la mano para combatir la plaga.
Las autoridades, hicieron un llamado a los representantes ganaderos para que transmitan el mensaje a los productores de bovinos, que la presencia del GBG no implica un cierre generalizado de ranchos o cuarentenas masivas.
Durante la reunión también se abordaron inquietudes y propuestas de diversos sectores productivos, incluyendo a un grupo de bufaleros, quienes presentaron temas enfocados en mejorar las condiciones para los productores de la región de Coatzacoalcos.
La reunión fue convocada por las uniones ganaderas del sur de Veracruz, donde también participó Rodrigo Calderón Salas, secretario de Desarrollo Agropecuario, Rural y Pesca del estado de Veracruz.

artísticas, exposiciones y actividades para toda la familia. Con estas acciones, el Gobierno del Estado reafirma su compromiso con el fortalecimiento del tejido social, el fomento cultural y el impulso turís-
»ENRIQUE BURGOS MUNDO
Coatzacoalcos, Ver.- Hasta el momento no se tienen los resultados sobre los estudios realizados en arroyos de los alrededores de la congregación de Mundo Nuevo, informó la agente municipal Karina Cobos.
La Comisión Nacional del Agua (CONAGUA), realizó una inspección en la zona y tomó muestras de afluentes, como parte de las investigaciones para determinar la peste química que afecta desde hace varios meses a los habitantes de la localidad.
Confirmó que los olores persisten, además de que la semana pasada se percibió otro a Amoniaco, lo que mantiene preocupados a los ciudadanos del lugar.
“En la semana viene el procurador a ver si ya ha arrojado algo, vamos a platicar con él porque salió una nota que iban a cambiar el monitor, no nos han dicho qué han arrojado las pruebas, eso vamos a platicar el martes porque como que nos están dando largas. Nada y ya la gobernadora dijo que era cerca de Cangrejera y aquí no nos han dicho nada. Seguimos igual, ahora se anexo el olor de amoniaco”, mencionó.

»ENRIQUE BURGOS
Coatzacoalcos, Ver.- La presencia de delfines en Coatzacoalcos significa que las aguas, en este momento, no están contaminadas.
Esteban Quintana de la Cruz, representante de la Sociedad Cooperativa Miguel Alemán, manifestó que la llegada de estas especies marinas antes no se daba tan cerca a las escolleras.
“Como ustedes han visto ahorita no hay contaminación, porque se han dado cuenta en la entrada de la bocana los delfines andan adentro, hace 15 días ahí andaban los delfines adentro.
Eso significa que no hay contaminación, antes no entraban los delfines hasta acá, y eso quiere decir que no hay contaminación, son unos animales tan fieles al ecosistema marítimo que nos avisan, pero no, ahorita todo está bien”, indicó.
Reiteró que, los pescadores han diversificado sus tareas actividades en la zona sur, pues también han colaborado en atención de derrames de hidrocarburo en el río.
Consideró que empresas dedicadas a la extracción de combustible los buscan debido a la labor y buen comportamiento que tienen.
tico.
Para más información sobre el calendario de eventos, se invita a consultar las redes oficiales de Sectur y SECVER, y en https://www.festivaldelmar.com.mx/.


El uso doméstico representa una mínima parte frente a la demanda productiva.
En Veracruz, más del 80% del agua concesionada por la Comisión Nacional del Agua (Conagua) se dirige a actividades agrícolas y productivas, según un análisis del Instituto para la Gestión, Administración y Vinculación Municipal (IGAVIM).
El estudio, basado en más de 29 mil concesiones otorgadas en la entidad, revela que el uso agrícola encabeza la lista con 1,965 millones de metros cúbicos anuales, sumando aguas superficiales (1,062 millones) y subterráneas (903 millones).
En segundo lugar, los usos múltiples
En Veracruz se han confirmado 37 casos de parálisis flácida aguda (PFA) hasta la semana epidemiológica 31 de 2025, con una tasa de incidencia de 1.8 por cada 100 mil menores de 15 años, según la Plataforma de la Dirección General de Epidemiología. En el mismo periodo de 2024, la entidad registró 47 casos, con una tasa de 2.2. La disminución en 2025 mantiene a Veracruz por encima del indicador mínimo establecido por la Organización Panamericana de la Salud (OPS) de 1 caso por cada 100 mil menores de 15 años, requisito para una vigilancia sensible de poliomielitis.
La PFA es un síndrome neurológico que puede tener diversas causas, incluida la poliomielitis. El sistema de vigilancia analiza muestras para descartar la presencia del poliovirus salvaje o derivados de la vacuna.
En lo que va de 2025, no se han detectado poliovirus en Veracruz, de acuerdo con las pruebas de laboratorio incluidas en la
o “diferentes usos” concentran más de 841 millones de metros cúbicos al año, distribuidos en 761 millones superficiales y 80 millones subterráneos. Estos incluyen permisos para obras públicas, infraestructura, recreación y otros fines oficiales.
El sector industrial cuenta con 367 concesiones que representan más de 710 millones de metros cúbicos anuales (631 millones superficiales y 79 millones subterráneos).
El uso público urbano dispone de 1,938 títulos para extraer más de 812 millones de metros cúbicos, provenientes de 499 millones superficiales y 312 millones subterráneos, destinados al abasto de ciudades y localidades.
USO DOMÉSTICO Y OTRAS ACTIVIDADES
El uso doméstico, con 126 concesiones, suma 1.29 millones de metros cúbicos superficiales y 138 millones subterráneos, proporción baja frente a otros sectores, pese al crecimiento urbano en municipios como Xalapa, Veracruz, Boca del Río y Coatzacoalcos.
Otros rubros son:
» • PECUARIO: 13.6 MILLONES DE METROS CÚBICOS ANUALES (485 TÍTULOS)
» • SERVICIOS: CASI 100 MILLONES (607 TÍTULOS)
» • ACUACULTURA: 44.8 MILLONES (56 TÍTULOS)
» • AGROINDUSTRIAL: 404 MIL METROS CÚBICOS (11 TÍTULOS)
El análisis de IGAVIM evidencia que la mayor parte del agua concesionada en Veracruz se concentra en el sector agropecuario e industrial, lo que plantea retos para la equidad y sostenibilidad en el acceso al recurso, especialmente en zonas con creciente escasez o conflictos por su distribución.
vigilancia nacional. México acumula 557 casos de PFA hasta la semana 31 de 2025, con una tasa de 1.7. En 2024, el total fue de
718 casos y tasa de 2.22. La vigilancia se mantiene activa como parte de la estrategia para la erradicación mundial de la poliomielitis.
»AVC
Xalapa, Ver.- El estado de Veracruz acumula hasta agosto de 2025 un promedio de 906.3 milímetros de lluvia, lo que representa un déficit de 22 por ciento respecto a las precipitaciones habituales, informó la Comisión Nacional del Agua (Conagua).
La jefa del área de Hidrometeorología de la Conagua, Jessica Luna Lagunes, explicó que 2025 se ubica como el doceavo año más seco desde que existen registros históricos. “Este 2025 se ubica en el lugar 12 entre los años más secos en el estado de Veracruz con un promedio de 906.3 milímetros de lluvia”, señaló. En lo que va de agosto, la precipitación se encuentra 82 por ciento por debajo de lo habitual. No obstante, Luna Lagunes precisó que en los primeros siete días del mes ha llovido el 20 por ciento de lo que llueve en promedio en todo agosto, lo que consideró suficiente para las condiciones actuales.
En julio, Veracruz se colocó en el lugar 27 entre los meses más secos desde 1941.

»AVC
Xalapa, Ver. - La Asociación Nacional de Padres de Familia en Veracruz solicitó a las autoridades estatales, en especial a la Secretaría de Seguridad Pública (SSP), poner en marcha el “Operativo Mochila” con el inicio del nuevo ciclo escolar. El delegado de la organización, Esteban Pablo Rodríguez Ortega, señaló que la medida es necesaria para identificar planteles y zonas con mayor riesgo en la entidad. Respaldó el operativo, pero sin intervención directa de elementos policiales. “Que se lleve a cabo con padres de familia y docentes porque de esta manera no se violentarían los derechos de los niños”, afirmó.
Rodríguez Ortega propuso que las revisiones se realicen sin previo aviso para detectar de inmediato artículos ilegales. “Cuando los hijos salen de la casa creemos que salen bien, pero en el trayecto pueden suceder muchas cosas, por eso es importante que se lleven a cabo estos operativos”, dijo.
Agregó que los padres pueden solicitar a la SSP la aplicación del programa si se presenta alguna situación de riesgo en los planteles.
El programa consiste en la revisión de pertenencias de estudiantes para impedir el ingreso de armas, drogas u objetos peligrosos, con el objetivo de mantener entornos escolares seguros. La medida involucra a padres, docentes y autoridades educativas.


REDACCIÓN
CIUDAD DE MÉXICO
¿Sabes todo el proceso que implica que tu destilado preferido haya llegado a un caballito (mejor aún, a una bonita copa tequilera) o sea el ingrediente principal de un gran coctel?
En el estado de Jalisco se creó una travesía por la zona tequilera para conocer, además de su proceso de elaboración, sus paisajes y una tradición entrañable que es parte de la identidad de México ante el mundo. Es el Tequila Express, uno de los productos turísticos que ofrece el estado hacia el pueblo mágico del mismo nombre. Todo comienza en la ciudad de Guadalajara por la mañana.
De hecho, hay un par de recorridos en tren por parte de diferentes empresas. Nosotros tomamos este, el que organiza la Cámara de Comercio de Guadalajara y Casa Sauza. Desde Zapopan se puede habilitar la transportación para llegar a la estación correspondiente ubicada en la capital, aunque lo más cómodo para muchos viajeros es llegar directamente a Guadalajara para abordar.
Los recorridos turísticos de este tren solo están disponibles los fines de semana, de viernes a domingo, y pueden ser sencillos o de ida y vuelta para quienes así lo prefieran.
UN TEQUILITA, UN
BOCADILLO Y UN PAISAJE
IRREPETIBLE
Antes de abordar, los pasajeros aprovechan el poco tiempo que tienen para tomarse las fotos del recuerdo, tanto en el vagón de cabeza como a lo largo de esta imponente máquina.
“Ofrecemos toda la experiencia: lo que incluye vivir un viaje en tren y disfrutar de la tradición en el proceso de elaboración del tequila”, explica Rafael Ramos Gómez, embajador de Casa Sauza.
El tequila es toda una tradición, por ello -agregó- es importante “educar” a las personas sobre el destilado, empezando por difundir el conocimiento del agave azul -el ingrediente fundamental del producto- y de las mejores combinaciones que se pueden lograr con la bebida.
Una vez que arranca el Tequila Express, los pasajeros se preparan para gozar de un trayecto de unas dos horas. Pero este no se reduce simplemente a viajar en un vagón: al asomarse a través de las ventanas panorámicas, descubren el icónico paisaje agavero, mismo que fue declarado Patrimonio de la Humanidad por la Unesco en 2006.
Esos extensos campos de cultivo se llaman “camas” de
agave azul que, por momentos, parecen tener principio, pero no fin.
Los municipios de Jalisco que integran aquel paisaje son varios: Tequila, Amatitán, El Arenal, Magdalena y Teuchitlán.
Elegimos el Vagón Bar, con más amenidades que el Vagón Ejecutivo. También pudimos probar distintos bocadillos y cocteles, y participar en una breve cata del tequila Tres Generaciones, en la que aprendimos un poquito a afinar nuestros sentidos: la vista, el olfato y el gusto.
Los interiores del tren son bastante amplios, decorados con muebles sobrios, pero elegantes. El Vagón Bar cuenta con una amplia barra y una sección de cómodos sillones.
Nos explicaron que Tequila Express, con el fin de hacer más disfrutable el viaje, guarda una velocidad de entre 50 y 60 kilómetros por hora.
Cuando llegamos al pueblo mágico de Tequila (la única parada) inicia otra experiencia. Nos trasladamos a un campo agavero de Casa Sauza. Un jimador, quien se dedica a cosechar la planta del agave, nos enseñó a plantar los ‘hijuelos’ del mismo, y nos mostró cómo cortar la que será una piña para trasladarla a las fábricas. No nos fuimos sin probar el centro del tallo o bola: nos recordó al sabor de la jícama.
Un aroma llama inmediatamente la atención en el territorio del agave; es intenso. Es la naturaleza en un proceso de reintegración: las hojas de la planta o pencas, que no se van a utilizar en el proceso, son llevadas a áreas específicas de los campos para que se descompongan y, posteriormente, sean devueltas a la tierra. El cierre de un ciclo ancestral.
EL TOUR EN LAS INSTALACIONES
La siguiente parada es Casa Sauza, donde los visitantes recorren tanto la bodega de añejamiento La Constancia como la fábrica La Perseverancia.
El origen mítico de la bebida, que es explicado por los anfitriones, se mezcla con los aromas de las barricas y los ruidos de las máquinas.
Ramos Gómez menciona que, en la actualidad, el tequila enfrenta grandes retos, como las dificultades en las exportaciones y el bajo consumo por parte de los adultos jóvenes. De hecho, diversos estudios internacionales indican que la generación Z puede ser la más sobria de todas, hasta ahora. “El tequila nos marca como mexicanos y que ha evolucionado considerablemente en sus procesos. No dudo que se

el trayecto, que va de Guadalajara al pueblo mágico de Tequila, disfruta del paisaje agavero y de unos cuantos tragos.
mantendrá como una de las más consumidas en el mundo”, concluye.
DE TEQUILA EXPRESS A UNA
EXPLOSIÓN SENSORIAL
Sabores y aromas rumbo a un pueblo mágico
Una vez que Tequila Express enciende motores, prepárate para la majestuosidad del paisaje agavero de Jalisco y para disfrutar de una cata tequilera en el Vagón Bar.
JIMADOR POR UN RATITO
En los campos agaveros, planta los hijuelos del agave azul y prueba el centro del tallo o labola de este, la que se convertirá en una piña para la elaboración del destilado
RECORRIDO POR LAS INSTALACIONES
Afina tu olfato y tu oído para la bodega de añejamiento. La
Constancia y para la fábrica
La Perseverancia; comprenderás qué hace que un tequila sea añejo o reposado. ¡Sorpréndete con el proceso automatizado del complejo!
A COMER Y A BEBER EN COMPAÑÍA DE UN MARIACHI
En la Quinta Sauza, alista el paladar para disfrutar de una torta ahogada o un postre. Por supuesto, no puede faltar la compañía del mariachi entre los distintos tiempos.
UN TEQUILA PARA CADA GUSTO
Participa en una cata sensorial,
En la sala Santoscoy, explota tu paladar con el tequila Tres

Generaciones en sus distintas variantes. Potencia el sabor de cada presentación, no solo con ingredientes como hierbabuena o especias, sino a través de cocteles a base de cítricos o café. Te dará sed de la mala.
VIAJE REDONDO
Aborda de nuevo el tren para cerrar tu viaje en Guadalajara. Disfruta de los colores del atardecer en el paisaje agavero y, sí, ¡de más tequila!







TALYA ISCAN
La reciente afirmación de Benjamín Netanyahu sobre la decisión de “ocupar totalmente Gaza” no representa una sorpresa. Es, más bien, la culminación de un proyecto sostenido de destrucción, desplazamiento y sometimiento de todo un pueblo, frente a una comunidad internacional que ha optado por mirar hacia otro lado. La diferencia ahora es el descaro. Ya no se oculta detrás del discurso de seguridad, ni de los rehenes, ni del antiterrorismo. La ocupación se nombra tal cual es: total, sin matices, sin negociación, sin consecuencias.
Desde el inicio de la escalada en octubre de 2023, la Franja de Gaza se ha convertido en el epicentro de una catástrofe fabricada. Decenas de miles de personas han muerto, muchas de ellas mujeres, niñas, niños, ancianos. Hospitales reducidos a escombros, redes de agua destruidas, panaderías bombardeadas y un bloqueo alimentario deliberado como método de presión. ¿Cómo se llama eso si no es un crimen de guerra? ¿Cómo se puede seguir justificando una política de hambre, privación y exterminio bajo el pretexto de defensa nacional?
La respuesta de Netanyahu a las críticas internacionales ha sido brutalmente clara: si el jefe del ejército no quiere seguir las órdenes de ocupación, que se vaya. Si las ONG denuncian hambruna, son propaganda. Si hay llamados a la contención desde las propias filas militares, se los descarta como ingenuidad. Este primer ministro no gobierna para la paz ni para la justicia: gobierna para sobrevivir políticamente, aferrado a una coalición de ultraderecha que solo se mantiene viva gracias al fuego cruzado, a los muros y al miedo. Y mientras tanto, ¿dónde están los guardianes del orden internacional? Estados Unidos no solo apoya esta operación: la respalda activamente. La Casa Blanca, bajo una presidencia trumpista reforzada, ha dado luz verde a esta fase final del asedio. No es pasividad, es complicidad. Washington continúa financiando y armando a un régimen que viola sistemáticamente el derecho internacional. ¿Y Europa? Divide su discurso entre la
“preocupación humanitaria” y el mantenimiento de relaciones estratégicas con Tel Aviv. Francia, el Reino Unido y Canadá han anunciado su intención de reconocer a Palestina como Estado en septiembre. Bien. Pero, ¿no es demasiado tarde? ¿Queda algo por reconocer en una Gaza arrasada, en una Cisjordania desmembrada por asentamientos, en una población atrapada entre las bombas y el bloqueo?
La cifra de países que reconocen al Estado palestino ya supera los 140. España, Irlanda, Noruega, México, incluso naciones del Caribe como Trinidad y Tobago y Barbados han dado un paso firme. Y sin embargo, la realidad sobre el terreno se vuelve cada día más irrecuperable. No hay autodeterminación posible bajo la ocupación. No hay Estado viable sin soberanía territorial, sin fronteras, sin dignidad. La narrativa occidental de los “dos Estados” se revela como una fantasía vacía, sostenida por diplomacias que nunca creyeron realmente en ella.
En Gaza no se libra solo una guerra entre Israel y Hamás. Se libra una guerra contra la posibilidad misma de que Palestina exista. Cada ataque, cada niño que muere de desnutrición, cada convoy humanitario bloqueado, es parte de una estrategia. No de defensa. De desaparición. De fragmentación de la memoria, del territorio, del tejido social palestino. No es una guerra clásica, es una guerra híbrida: diplomática, informativa, territorial, económica, psicológica. Y la comunidad internacional —con algunas excepciones— se ha convertido en espectadora, cuando no en socia directa de ese proceso.
¿Hasta cuándo se permitirá que Israel actúe por encima del derecho internacional sin rendir cuentas? ¿Cuántas veces más se pronunciarán las palabras “derecho a defenderse” mientras Gaza se desangra? ¿Qué legitimidad puede tener un orden internacional que calla frente al hambre, frente a los crímenes documentados, frente al colonialismo del siglo XXI? ¿Y qué hará México, país históricamente defensor del multilateralismo, cuando llegue el momento de votar una resolución decisiva en la ONU?
SOSTIENE PEREYRA
Vencieron a los chinos y en calidad de campeón mundial. El clavadista Osmar Olvera y su entrenadora Ma Jin pidieron públicamente que le aumentaran el sueldo y se le otorgue un seguro médico para que la china siga trabajando en México. El tema expone un tema más complejo: los entrenadores mexicanos —al igual que los deportistas— no son asalariados, sino becarios, por ende, no tienen seguridad social.
El sueldo de Ma Jin, y el de los entrenadores chinos se paga a través de un convenio llamado Colaboración y Programas de Actividades Deportivas México-China que se firma cada año. Ma Jin es la jefa, razón por la cual es la que más gana. China le presta a México a estos entrenadores quienes saben que no tienen derechos laborales. Este escenario no dista mucho de las condiciones en las que siempre han estado los mexicanos. Mientras tienen resultados, reciben una beca; cuando el rendimiento de sus deportistas baja debe ser ajustada. Todo es por tabulador. Los entrenadores de los medallistas olímpicos tampoco reciben una beca vitalicia, luego entonces el reclamo de Ma Jin no debe ser sólo para ella, sino de todos aquellos que se dedican al deporte.
Esta situación ha generado que los entrenadores busquen ser contratados en sus respectivos estados e incluso en universidades públicas o privadas para completar. Los premios económicos que obtienen también les ayudan. A muchos no les va mal, ya con varias fuentes de ingresos la libran y encuentran quien les dé seguridad social.
¿Llegó el momento de definir una política pública para ese trabajo llamado entrenador deportivo? Algunos han recurrido malamente a pedirle a sus deportistas que les den parte del dinero que ganan. Iván Bautista, entrenador de clavados, también ha ayudado a ganar medallas olímpicas.
Con AMLO se eliminó la prestación del seguro de gastos médicos para los empleados del gobierno federal. Recordemos que incluso a Bautista, por las pistolas de Ana Guevara, le dejaron de pagar su beca y estuvo meses sin cobrar hasta que mediante un juicio de amparo logró recuperar su dinero.
Ma Jin también estuvo a merced de Guevara. A ella la amenazó con dar por terminado el Convenio MéxicoChina si acompañaba a Osmar Olvera a sus competencias internacionales.
Fueron Bautista y Jahir Ocampo, asistente de Ma Jin, quienes ayudaron a Osmar durante 2024 para que no se quedara solo. Ahí queda otro tema que Rommel Pacheco, director de la Conade, debe resolver. Trabajar para el deporte implica atender estas problemáticas.
Desde que asumió como director, Ma Jin le pidió una solución. Tuvo que decirle a la presidenta Claudia Sheinbaum para ser atendida. Rommel baila mucho, pero soluciona poco.

ISRAEL LÓPEZ GUTIÉRREZ
Desde hace dos años, el presidente de El Salvador, Nayib Bukele, ya había dado una probadita de que su meta era no dejar el mando; por eso los jueces reinterpretaron la Constitución para que pudiera reelegirse 5 años más. Hoy, no es necesario ese tipo de chanchullos, porque ya le limpiaron el camino para perpetuarse en el poder.
Por amplia mayoría y con todo el cinismo del que se es posible, el Congreso salvadoreño, que controla Nuevas Ideas –partido del dictador Bukele–, avaló una drástica reforma constitucional que permite la reelección presidencial indefinida.
La reforma obtuvo el apoyo de 57 de los 60 parlamentarios del Congreso; además, el período presidencial pasa de 5 a 6 años y elimina la segunda vuelta electoral. Al respecto, Bukele dijo que no le importa que le llamen dictador, pero eso tal vez no sea tan cierto.
El presidente salvadoreño siempre ha dado muestras de ser poco tolerante con la crítica, busca controlar completamente lo que se dice y lo que se conversa en todos los niveles de la vida social de El Salvador.
Más allá de eso, el partido de Bukele le dejó bien planchado el camino para que la reelección se convierta en solo un trámite y él pueda seguir pregonando que gobierna bajo una democracia, que, por cierto, con esta reforma ya murió en El Salvador.
A todas luces, Nuevas Ideas impulsó y aprobó una de las herramientas más rancias de los regímenes totalitarios. Seguramente Bukele sintió envidia de su vecino el nicaragüense
Daniel Ortega, quien solo dejará el poder hasta que muera. Bueno, pero esa es harina de otro costal.
Súmele que el omnipotente Bukele hoy en día es el mandatario consentido de su par estadounidense, Donald Trump, y por eso puede hacer lo que mejor le venga en gana; no hay que olvidar que es el carcelero estrella del magnate. El presidente salvadoreño se ha especializado en recluir bajo condiciones extremas a los migrantes indocumentados que le manda el gobierno de Estados Unidos, sin importar que se estén violentando sus garantías. Primero se entrenó con los pandilleros, pero ahora reprime por pedido.
Por supuesto, el republicano Trump no se ha pronunciado por la nueva travesura de su aliado consentido y no es para menos, porque el magnate también ha dejado entrever que el Congreso de su país debería hacer algo para que él se pueda reelegir. Faltaba más.
Bukele ha sabido cómo granjearse la amistad de Trump. En 2024, participó en la Conferencia Anual de Acción Política Conservadora que se realizó en Estados Unidos; ahí dijo al público que tomaran a El Salvador como advertencia y relató cómo las pandillas tomaron el control de su país, con lo que justificó su lucha para arrestar a los criminales.
Aunque hoy en día las pandillas están en vías de extinción en las calles y barrios de El Salvador, más de 60 mil pandilleros están recluidos; desafortunadamente para los salvadoreños, lo único que no se ha podido erradicar es el miedo. Hay Bukele para rato.
LA
Al menos tres veces por semana, las cuentas oficiales del Gobierno de Estados Unidos y sus dependencias publican algún tipo de meme para alabar a la administración actual. En otro tiempo, la Casa Blanca reservaba sus cuentas para comunicados, discursos y datos. Hoy se han convertido en un espacio donde la derecha predica un humor propagandístico. El resultado es un gobierno que comunica como influencer.
Sus seguidores compran la idea de que es divertido, de eso no hay duda. Sin embargo, detrás hay un Estado que incorpora recursos de propaganda visual los legitima cuando los presenta con sellos institucionales. Si antes los memes se usaban para criticar el poder, ahora varios se utilizan al servicio del poder y se han vuelto, en parte, su lenguaje oficial. En otras palabras, el Estado habla en memes.
¿Qué significa que la potencia mundial se comunique con su población (y el resto) en clave de meme? Un efecto inmediato es el desplazamiento de la parte informativa de las cuentas oficiales para dar prioridad a las emociones que provocan. Para ello, el Estado ha aprendido a construir una realidad a través del troleo. Durante el auge de las imágenes generadas por IA “al estilo Ghibli”, la cuenta oficial de la Casa Blanca publicó la imagen de una mujer detenida para ser deportada.
De hecho, han utilizado varias tendencias de internet para legitimar arrestos y deportaciones. Más que un recurso humorístico, se trata de un ejercicio que entrena a la audiencia para leer la coerción como entretenimiento y la autoridad como una puesta en escena carismática. Esos actos de crueldad se presentan como inofensivos: el meme los vuelve digeribles y, por repetición, terminan por normalizarse.
¿Estamos en un punto máximo? Tal vez. Lo que ha hecho la administración de Trump con los memes no tiene precedentes. Son publicaciones semanales, varias con cientos de miles de “me gusta”.
Será interesante observar si otros gobiernos (sobre todo los de derecha) replican ese uso de los memes en redes sociales. Habrá que ver si se convierte en una forma de gobernar o si queda como un rasgo más, en el recuerdo de la administración de Trump, por lo surreal que fue. Eso sí, lo que antes significaba formalidad y seriedad en el gobierno de Estados Unidos se ha perdido, pero no por ello el ejercicio del poder resulta menos cruel.
Las ondas gravitacionales son perturbaciones en el espaciotiempo, las cuales son invisibles y extremadamente rápidas, y se crean cuando los objetos se mueven a velocidades muy altas.
REDACCIÓN
CIUDAD DE MÉXICO
Aunque Albert Einstein predijo su existencia en 1916, como una consecuencia de su Teoría de la Relatividad General, las ondas gravitacionales se pudieron detectar casi 100 años después, el 14 de septiembre de 2015, pese a que había evidencia indirecta de ellas desde la década de 1970, relató Miguel Alcubierre Moya, investigador y exdirector del Instituto de Ciencias Nucleares (ICN) de la UNAM.
El doctor en física explicó que las ondas gravitacionales son perturbaciones en el espacio-tiempo, las cuales son
invisibles y extremadamente rápidas, y se crean cuando los objetos se mueven a velocidades muy altas.
Se generan en algunos eventos astrofísicos muy violentos, como la explosión de supernovas (estrellas en su fase final de vida), colisiones de agujeros negros o estrellas de neutrones. “Se producen en el espacio desplazándose a la velocidad de la luz –la cual es de 300 mil kilómetros por segundo– y se extienden de forma semejante a las ondas que se generan en un cuerpo de agua al lanzar una piedra”, detalló.
Capaces de contraer y estirar cualquier cosa que encuentran a su paso, si pasaran a través de nosotros nos haríamos altos y flacos, y después gordos y bajos,
una y otra vez, dijo ante los asistentes a una conferencia magistral sobre el tema, con la cual se clausuró el 11° Encuentro universitario de mejores prácticas de uso de TIC en la educación. Educatic 2025.
En el Auditorio Manuel Sánchez Rosado de la Escuela Nacional de Trabajo Social, Alcubierre Moya acotó que, desde hace más de una década, las ondas gravitacionales se pueden detectar con observatorios como LIGO en Estados Unidos, Virgo en Italia, GEO 600 en Alemania y KAGRA en Japón.
CONTRADICCIONES,
AVANCE DE LA CIENCIA
Haciendo un poco de historia, el científico describió que la teoría clásica de la gravedad es la Ley de Gravitación Universal de Isaac Newton, que explica la caída de los objetos y las órbitas de los planetas.
“Esta teoría tiene un serio inconveniente, pues supone que la gravedad actúa de manera instantánea: si alguien moviera el Sol, la Tierra lo notaría inmediatamente. Esta ‘acción a distancia’ no le gusta-


ba a Newton, pero consideraba que tendría que dejarse así hasta que se entendiera mejor la naturaleza de la gravedad”. Precisó que el problema empeoró cuando Albert Einstein desarrolló la Teoría de la Relatividad General, que mostró que nada podía viajar más rápido que la luz y que nada puede actuar de manera instantánea.
Einstein dedicó una década a buscar una nueva teoría de la gravedad. “Este esfuerzo culminó en 1915 con la Teoría de la Relatividad General, que predice que la gravedad no es instantánea, sino que se propaga precisamente a la velocidad
de la luz”, indicó.
El investigador universitario agregó que la Teoría de la Relatividad General no es una modificación pequeña de la teoría de Newton, sino una revolución en los conceptos de espacio y tiempo.
“De acuerdo con la Relatividad General, el espacio y el tiempo no son rígidos. La geometría del espacio y el flujo del tiempo se modifican por la presencia de concentraciones de masa y energía: el espaciotiempo se curva”.
Así como el electromagnetismo predice las “ondas electromagnéticas” (como luz y ondas de radio), la Relatividad


General lo hace con las “ondas gravitacionales”: perturbaciones en el espacio-tiempo que se propagan a la velocidad de la luz.
Las ondas gravitacionales se crean cuando los objetos se mueven a velocidades muy altas. Las pueden generar la explosión asimétrica de una supernova, dos estrellas grandes que se orbitan una a la otra y dos agujeros negros que orbitan entre sí y se fusionan. Pero estos tipos de objetos en el universo están muy lejos, y a veces dichos eventos sólo causan ondas pequeñas. Cuando llegan a la Tierra, las ondas gra-
vitacionales –que resultan muy difíciles de medir– son muy débiles, expuso el investigador universitario.
EDUCATIC 2025
Con el fin de visibilizar experiencias docentes que integran tecnología para mejorar los procesos de enseñanza y aprendizaje, así como contar con un espacio colaborativo de reflexión y análisis sobre el proceso que siguen las y los profesores para formar al estudiantado, se realizó la 11 edición del Encuentro universitario de mejores prácticas de uso de TIC en la educación. Educatic 2025.
Organizado por la Dirección General de Cómputo y de Tecnologías de Información y Comunicación (DGTIC), este evento tuvo lugar del 29 de julio al 1° de agosto. Durante los cuatro días del encuentro, hubo mesas de diálogo, conferencias y talleres, actividades en las que estuvieron (de manera presencial o remota) 614 participantes nacionales e internacionales, provenientes de México, Venezuela, Ecuador, Colombia y Panamá, informó Marina Kriscautzky Laxague, directora de Innovación en Tecnologías para la Educación de la DGTIC.


ISAAC NEWTON, CIENTÍFICO Y ALQUIMISTA
El 20 de marzo de 1727 del calendario juliano, 31 de marzo en el calendario gregoriano, entonces en vigor en Inglaterra, murió sir Isaac Newton, quien días más tarde fue enterrado en la abadía de Westminster en un funeral donde se dio cita prácticamente toda la intelectualidad de Gran Bretaña y buena parte de su aristocracia.
Se rendía homenaje a un hombre de ciencia, a un matemático, a un filósofo natural y al primer científico nombrado caballero por la reina en la historia de aquel país. A su muerte
ocupaba la presidencia de la Royal Society, era miembro de la Comisión de Longitud y su influencia fluía por todos los canales de la cultura británica. A un asistente al funeral procedente de Francia y de sobrenombre Voltaire le sorprendió que la sociedad británica honrara la figura de un sabio. Isaac Newton murió octogenario y con la fama de poseer una mente con una capacidad extraordinaria para dominar las ciencias más difíciles: las matemáticas y el cálculo, la mecánica de los cuerpos celestes y el comportamiento de la luz.


Aunque a nivel nacional las remesas representan 3.5% del producto interno bruto (PIB), en algunas entidades la dependencia sobre esos recursos es significativamente mayor.
REDACCIÓN
CIUDAD DE MÉXICO
La caída esperada este año en el flujo de remesas que ingresa a México pone en riesgo la salud financiera de hogares de menores recursos, en los cuales la recepción de esos recursos supera en algunos casos 30% de sus ingresos.
Analistas económicos anticipan una reducción de entre 4% y 6% en las transferencias que realizan desde el extranjero los paisanos a sus familias, sobre todo los que emigraron a Estados Unidos, reflejando ya la debilidad en el sector laboral del país vecino, las políticas migratorias agresivas del presidente
REDACCIÓN PACHUCA, HIDALGO
En Hidalgo, la Presidenta Claudia Sheinbaum Pardo supervisó la construcción del tren de pasajeros México-Pachuca, que presenta un 4 por ciento de avance y se espera que esté listo para el primer semestre de 2027, para conectar a las familias de ambas ciudades en un tiempo de recorrido de una hora 15 minutos beneficiando a 108 mil pasajeros al día.
“El tren, de esta forma, no solamente es una obra pública fundamental que va a generar empleos, que va a conectar ciudades, en esencia conecta familias, conecta desarrollo. Este tren queremos que esté listo en el primer semestre del 2027 y estamos trabajando en equipo”, informó.
Donald Trump, así como un tipo de cambio más favorable al peso. De acuerdo con el Anuario de Migración y Remesas 2025 de BBVA, publicado el miércoles pasado, en hogares receptores de remesas más de 30% de sus ingresos corrientes provienen de esa fuente. Así, la proporción combinada de ingresos por remesas y trabajo puede llegar a 67%, superando las percepciones laborales de familias que no reciben remesas, en las cuales representan un promedio de 64.4%.
Aunque a nivel nacional las remesas representan 3.5% del producto interno bruto (PIB), en algunas entidades la dependencia sobre esos recursos es sig-
nificativamente mayor. Chiapas tiene la mayor proporción, con 14.6% de su PIB originado por esa vía, y le siguen Guerrero (14%), Michoacán (11%), Zacatecas (10.9%) y Oaxaca (10.3%).
El caso de Chiapas destaca, pues históricamente no figuraba entre los estados con mayor dependencia de las remesas, pero recientemente su situación cambió de manera acelerada, influida en parte por los flujos migratorios de Centro y Sudamérica.
En contraste, Campeche, Tabasco y Nuevo León registran un impacto mínimo, con porcentajes que van de 0.5% a 0.9% del PIB, lo que muestra el efecto desigual de la fluctuación de las remesas en distintas regiones del país.
LIMITACIONES
La capacidad de las remesas como factor amortiguador se verá cada vez más limitada por los posibles cambios en la política migratoria o la adopción de otras medidas por parte de Estados Unidos, como un mayor control sobre el envío de fondos o la aplicación de impuestos y gravámenes que encarecen las transferencias, alertó la Comisión Económica para América Latina y el Caribe (Cepal) en su último Estudio Económico regional.

Puntualizó que ya se encuentran liberados los derechos de vía para esta obra de más de 57 kilómetros (km), lo que va a permitir registrar un avance mayor en la construcción de esta línea.
Recordó que la inversión para conectar a la ciudad de Pachuca con el Aeropuerto Internacional Felipe Ángeles (AIFA) es de 47 mil millones de pesos (mdp); mientras que el tramo de Lechería al AIFA es de 27 mil mdp.
Resaltó que la construcción de este tren es parte del Plan México, ya que va a facilitar la conectividad de los Polos de Desarrollo para el Bienestar en el país, específicamente el que se va a ubicar en el estado de Hidalgo, sobre un terreno de
»REDACCIÓN
CIUDAD DE MÉXICO- Los pueblos indígenas custodian lenguas, ritos, símbolos y saberes que son fruto de siglos de relación armoniosa entre comunidades, consideró la Iglesia Católica al explicar que su modo de entender la vida no es un vestigio del pasado: es una fuente de sabiduría para el presente y una brújula para el futuro.
“Estas comunidades, muchas veces marginadas y despojadas, han resistido con dignidad a pesar de la incomprensión y la exclusión, del abuso de poderosos que han considerado inferiores sus valores, sus culturas y sus tradiciones”, indicó a través de la editorial Desde la Fe.
Aseguró que son guardianes de valores esenciales: el respeto por la naturaleza, la centralidad de la familia y la comunidad, la gratitud por los dones recibidos, y la conciencia de que la vida es un regalo que se cuida en cada etapa.
“Reconocer el valor de los pueblos originarios implica mucho más que admirar su folclore o preservar sus artesanías. Significa abrir un espacio real para que su voz tenga peso en las decisiones que afectan sus territorios, su medio ambiente y su forma de vivir”, mencionó la Iglesia.

Escasea vivienda económica
»REDACCIÓN
CIUDAD DE MÉXICO- La escasez de vivienda media y económica no es exclusiva de las grandes ciudades del país, pues en los principales destinos de playa también hay poca oferta de esas opciones para quienes no son turistas o extranjeros. En la Riviera Maya, Puerto Vallarta y Los Cabos, las tres principales zonas de playa, hay un desbalance en la oferta de vivienda, pues los proyectos en segmentos premium o de lujo dominan el inventario, de acuerdo con la consultora 4S Real Estate. Esto abre una oportunidad para desarrollar vivienda para quienes llegan a trabajar a estos destinos turísticos y para quienes nacieron ahí.
Arturo Garcidueñas, socio regional Sureste de 4S Real Estate, dijo que en estas zonas hay interés por inmuebles de gama media, pero las condiciones estructurales actuales dificultan su desarrollo.
“La distribución por segmento en las principales ciudades de playa está desbalanceada. Vemos una concentración relevante en los niveles altos y una oferta prácticamente inexistente en el segmento medio.
950 hectáreas que permita el desarrollo industrial, de vivienda, escuelas y hospitales.
El comandante del Agrupamiento de Ingenieros Felipe Ángeles de la Secretaría de la Defensa Nacional, general Ricardo Vallejo Suárez, detalló los avances técnicos del proyecto distribuidos en cinco frentes de vía férrea y edificación: un frente de catenaria y electrificación; dos frentes de subestaciones eléctricas; y dos frentes de estudios técnicos de preinversión y ejecución para garantizar la entrega de la obra en los tiempos comprometidos. Agregó que actualmente hay activos 4 mil empleos y se estará incrementando conforme avance la obra.
“Factores como el precio del suelo, tasas de interés y costos de construcción hacen inviable generar ese producto, pese a que la pirámide poblacional lo exige con urgencia”, explicó Garcidueñas, al presentar el Panorama Inmobiliario The Talks México 2025 Edición Playas.


El gobernador
puso en
marcha
el Centro LIBRE del Programa
de Atención Integral para el Bienestar de las Mujeres y recorrió sus instalaciones junto a la secretaria de la Mujer e Igualdad de Género.
REDACCIÓN
LARRÁINZAR, CHIAPAS
El gobernador Eduardo
Ramírez Aguilar encabezó una intensa gira de trabajo por Larráinzar, donde inauguró diversas obras en beneficio de las comunidades, reiterando su respaldo para impulsar el desarrollo de este municipio de la región Altos Tsotsil-Tseltal. En la cabecera municipal, puso en marcha el Centro LIBRE del Programa de Atención Integral para el Bienestar de las Mujeres y recorrió sus instalaciones junto a la secretaria de la Mujer e Igualdad de Género, Dulce María Rodríguez Ovando, quien explicó que este espacio
comunitario cuenta con personal profesional y especializado para atender casos de violencia de género, brindando orientación legal, atención psicológica, acompañamiento, canalización y talleres formativos.
Posteriormente, en las localidades Muctahuitz y Chuchiltón, Ramírez Aguilar inició las obras de ampliación de la red de distribución de energía eléctrica que, dijo, además de responder a una añeja demanda, contribuirán al bienestar y progreso comunitario. Ante las y los habitantes, reafirmó su compromiso de mantenerse cercano a la gente para escuchar y atender las necesidades de los pueblos originarios.


“Soy un gobernador que no solo llega a las cabeceras municipales, sino que camina todas las comunidades porque es la única manera de conocer lo que la gente necesita. No tomamos decisiones desde la oficina, sino desde el territorio”, expresó al tiempo de hacer un llamado a la unidad y fraternidad para preservar la paz y la prosperidad.
La secretaria de Infraestructura, Anakaren Gómez Zuart, detalló lo realizado en cada obra, precisando que, en Muctahuitz se destinó una inversión superior a 18 millones 289 mil pesos y en Chuchiltón, 16 millones 817 mil pesos.
Más tarde, el gobernador dio el banderazo de arranque a la construcción del Entronque Carretero Larráinzar–Santo Domingo–Chuchiltón, subrayando que el gobierno de la Nueva ERA impulsa la moder-


nización de la infraestructura carretera para mejorar la conectividad y detonar la economía de las comunidades. Puntualizó que esta obra representa seguridad, rapidez en los traslados y, sobre todo, esperanza para quienes diariamente recorren la región para trabajar y comercializar sus productos.
El director general de la Comisión Estatal de Caminos, Rafael Ruíz Morales, resaltó que en la construcción de este tramo carretero se invertirán más de 10.5 millones de pesos, beneficiando a 32 mil 140 habitantes.
En otro momento, el mandatario visitó la comunidad Majoval, donde inauguró obras en el Centro de Educación Preescolar “Luz del Saber” y en la Escuela Primaria “Cuauhtémoc”. Durante su mensaje, sostuvo que la justicia implica garantizar mejores
aulas, educación de calidad y condiciones de vida dignas. Reafirmó su compromiso de seguir trabajando de la mano del pueblo y de brindar mayor atención a las mujeres, para erradicar la violencia en su contra.
El director general del Instituto de la Infraestructura Física Educativa, Carlos Ildelfonso Jiménez Trujillo, explicó las obras de ambos planteles e indicó que en el preescolar se invirtieron más de un millón 163 mil pesos, mientras que en la primaria más de 2 millones 912 mil pesos.
Por su parte, la secretaria para el Desarrollo Sustentable de los Pueblos Indígenas, Leticia Méndez Intzin, y el alcalde de Larráinzar, Andrés Ruiz Gómez, reconocieron al gobernador como un aliado comprometido con los pueblos originarios.













Este programa de verano itinerante que busca brindarles entretenimiento, aprendizaje y servicios gratuitos durante las vacaciones.
REDACCIÓN
COATZACOALCOS, VER.
Más de cien niños y niñas de la colonia Santa María disfrutaron la mañana de este viernes de diversas actividades recreativas, culturales, educativas y de salud durante el programa ‘Verano en tu colonia’ que les ofreció el gobierno de Coatzacoalcos a través de la dirección de Educación.
En la escuela primaria Tlacaelel, la titular de la dependencia, Adriana Yolanda García Garay, invitó a los habitantes de esta colonia a disfrutar de este programa
Nunca más un México sin los pueblos originarios: Bautista
REDACCIÓN
XALAPA, VER.
“Nunca más un México sin los pueblos originarios”, expresó con firmeza, en la víspera del Día Internacional de los Pueblos Indígenas, el diputado Esteban Bautista Hernández, al encabezar un Encuentro Informativo en la cabecera municipal de Jáltipan, donde entregó de manera simbólica el Artículo 5 de la Constitución Política del estado a integrantes del Comité de Seguimiento de la sede Mecayapan. En presencia de las diputadas Naomi Edith Gómez Santos, Ingrid Jeny Calderón Domínguez e Ivonne Selene Durán López, y de la representante del Club de Mujeres Libres del Tatahuicapan, profe-
de verano itinerante que busca brindarles entretenimiento, aprendizaje y servicios gratuitos durante las vacaciones.
“Agradecemos a la institución que abre las puertas; hoy venimos con mucho amor a traer varias actividades donde los niños van a desarrollar habilidades, van a haber juegos, piñatas, dulces y mochilas con útiles escolares que se van a rifar, lo traemos con mucho amor para los padres y los alumnos que son el presente y el futuro”, dijo.
García Garay destacó la suma de voluntades de la regiduría Segunda, Salud Pública, Desarrollo Agropecuario,
Desarrollo Social, Cultura, Quetzalli, ICATVER, Integra, CMAS y empresas locales: “Todos los que venimos aquí somos unos guerreros porque trabajamos por el bien de los niños”.
La regidora Segunda, María Sandra Collins Coronel, en representación del alcalde Amado Cruz Malpica, felicitó a los padres de familia por acompañar a sus hijos y formar parte de estas actividades:
“Esperamos que estas cuatro horas que estaremos aquí lo disfruten mucho y aprovechen todo lo que traemos para que se lleven un buen mensaje y un buen aprendizaje”.
Este día, chicos y grandes disfrutaron de baile y canto, atención médica, elaboración de huertos, corte de cabello, juegos didácticos, pláticas sobre el respeto al medio ambiente, dibujo y pintura, taller de repostería, taller de cuidado del agua, aplicación de flúor, cuentacuentos, alimentación saludable, dulces y sorpresas.
El próximo viernes 15 de agosto ‘Verano en tu colonia’ cerrará en la cancha del Centro de Desarrollo Comunitario Cuauhtémoc en la colonia Rafael Hernández Ochoa. Se invita a la ciudadanía acudir y aprovechar estas acciones sin costo.

sora Minerva Galán Quinta, el legislador señaló que anteriormente los indígenas, los pueblos olvidados de siempre, únicamente servían como voto cautivo en tiempos electorales. Hoy, en cambio, -afirmó- gozan del reconocimiento legal y son sujetos de derecho público con libre determinación.
Ante habitantes, autoridades y representantes indígenas, el diputado manifestó que “nunca en la vida habíamos visto un abanico de acciones que beneficiaran a este sector tan olvidado” y constató que “hoy se dignifica ese México herido, ese México olvidado, esos indígenas que muchos años estuvieron sin voz, olvida-
dos en su pobreza y en sus enfermedades y olvidados de la patria”. Al hacer un contraste con el país que marginó a los indígenas, aseveró categóricamente que, “de la mano de la presidenta de la República, Claudia Sheinbaum Pardo y de la gobernadora de Veracruz, Rocío Nahle García, hoy México y Veracruz caminan firmemente por la vía de la transformación viendo siempre las necesidades de todos” y anunció que recorrerá el estado para informar a todas las comunidades acerca de los derechos, en materia de autodeterminación, gobierno y administración de los recursos, de que ya gozan a partir de dicha reforma.
LUNES 11 DE AGOSTO DE 2025
»REDACCIÓN
Coatzacoalcos, Ver.- El municipio de Coatzacoalcos participa en la Undécima Reunión de la Red Veracruzana de Municipios por la Salud (RVMS), con sede en Minatitlán, con el objetivo de fortalecer la coordinación y las estrategias para combatir enfermedades que representan un riesgo para la población.
En representación del presidente municipal, Amado Cruz Malpica, el doctor Javier Reyes Muñoz, director de Desarrollo Social y Salud Pública Municipal, señaló que Coatzacoalcos se encuentra listo para dar cumplimiento a los temas prioritarios de la agenda de salud.
Uno de los puntos principales fue la implementación de acciones municipales para la prevención y el control de enfermedades como el paludismo y la rickettsiosis, las cuales requieren una vigilancia constante para disminuir el riesgo.
También se hizo hincapié en la necesidad de reforzar las estrategias para prevenir las enfermedades transmitidas por arbovirosis, con especial énfasis en el dengue, así como la colaboración entre municipios para intensificar las campañas de fumigación y concientización sobre la eliminación de criaderos de mosquitos.
Finalmente, la reunión se enfocó en la importancia de continuar con las acciones municipales para la prevención y detección oportuna del VIH/sida y facilitar el acceso a información oportuna.

Concluye curso de verano ‘Mis Vacaciones en la Biblioteca 2025’ »REDACCIÓN
Coatzacoalcos, Ver.- Luego de tres semanas de aprendizaje y mucha diversión, culminó el curso de verano ‘Mis Vacaciones en la Biblioteca 2025’ con la participación de 240 niños y niñas de 6 a 12 años que asistieron a las siete bibliotecas municipales de Coatzacoalcos y al módulo del ejido Colorado.
La clausura oficial se llevó a cabo la mañana de este viernes en la biblioteca Oralia Bringas de García, con la entrega de parte de autoridades municipales de constancias de participación a los pequeños que acudieron del 21 de julio al 8 de agosto y formaron parte de este programa cultural.
La jefa de Bibliotecas, Katia Carrillo Cervantes, resaltó que en cada curso de verano estos centros de estudios se llenan de alegría y energía positiva con la visita de los infantes, provocando que todos los que trabajan en esta dependencia quieran hacer las cosas cada vez mejor.


veces, yo me he callado miles de cosas por proteger justamente las cosas maravillosas que pasamos juntos, nos casamos por la iglesia, tuvimos dos hijos, y ahora se va a tratar de desacreditar esos 16 años que pasamos juntos… ¿tanto coraje me tienes nada más porque te pedí el divorcio?, porque no te pinte el cuerno, no te dejé en la calle”.
El Servicio Nacional de Salud (NHS), entidad que está llevando adelante el programa masivo de vacunación de coronavirus en el Reino Unido, publicó varias fotos del actor británico, vestido con una playera azul y una bufanda multicolor, levantando el pulgar al recibir la inyección.
co”, declaró Ana a su llegada al evento 31 mujeres que amamos organizado por la revista Quién.
tipo de fama global en los 2000, cuando interpretó a Gandalf en las cintas dirigidas por Peter Jackson y a Magneto en X-Men.
Al respecto, Ana Serradilla declaró que le parece triste que, a pocos días de su boda, Martha Cristiana revele estos pasajes de su vida y más aún cuando su matrimonio con el empresario terminó hace cinco años.
“Es un día muy especial, me siento eufórico. Me siento muy afortunado de haber recibido la vacunación. Realmente espero que, a medida que más personas se vacunen, avancemos en el camino de regreso a una forma de vida más normal”, dijo McKellen, de 81 años.
Casi 140 mil personas han recibido la primera
“Fue fuerte y un poco triste porque este divorcio se dio hace cinco años aproximadamente y tener estas declaraciones fue como ‘Wow, justo a días de la boda’, pero bueno, todo pasa por algo y yo no puedo ni juzgar ni nada, Raúl sabrá cómo manejarlo y cómo
La estrella de cine y teatro es la última celebridad británica en difundir que recibió la vacuna de covid-19, parte de un esfuerzo colectivo por llevar tranquilidad a la población con dudas sobre su seguridad.
La protagonista de películas como El hubiera si existe y La boda de mi mejor amigo resaltó que es muy delicado hacer juicios o hablar de algo que no le consta, porque lo único que ha recibido de su prometido desde que lo conoció son buenos tratos y mucho amor.
“Es muy delicado emitir juicios porque no conocemos la otra cara de la moneda. Yo por eso trato de mantenerme al margen porque es un tema bien delicado, cualquier cosa que yo diga no aplica en este caso”.
No se sabe si la reina Isabel, de 94 años, y su esposo, el príncipe Felipe, de 99, ya han recibido la vacuna. La monarca es muy respetada en el Reino Unido y su apoyo daría un mensaje poderoso para contrarrestar la desinformación sobre la vacunación.
nivel mundial y fue nominada para el Premio de Cine Alemán al Mejor Largometraje en 2019. Cabe resaltar la formidable pareja actoral de Mauricio Ochmann y Ana Serradilla, rodeados de un elenco estelar en el que participan:Diana Bovio, Irán Castillo, Regina Pavón, Ana Claudia Talancón, Norma Angélica, así como David Chocarro, Ricardo O´Farrill, Roberto Sosa y Fernando Cuautle. “25 km/H” narra la historia de dos hermanos que se reúnen en el funeral de su padre y toman la decisión espontánea para cumplir el sueño de su juventud y conducir por México en sus viejas motocicletas. La aventura a campo traviesa les permite enmendar su relación y traer un nuevo propósito a sus vidas.
Además aclaró que Aislinn siempre ha sido partidaria de tomar terapia, independientemente de los problemas que existan o no en su vida. “Mi hija toma terapia siempre. Es fan de la terapia. Esté bien o esté mal, a cada rato me dice: ‘papá toma terapia, te hace muy bien para tu día a día. No te esperes a tener una crisis para tomar terapia’. Posiblemente si la vieron saliendo de alguna terapia: sí, va a terapia, va a terapia con Mauricio, ya me recomendó una terapia para Alessandra y para mí. Y si vamos no es que nos estemos separando tampoco, es nada más para sanar la relación y no se rompa el día de mañana”, puntualizó.
¿Qué virtudes destacas en el actual periodismo cultural; hacia dónde crees que se dirige el periodismo en general en esta época de cambios vertiginosos?
fuera su descanso.
“Es un reconocimiento a ellas por ese profesionalismo, ese humanismo que tienen para venir. Son niños, son vidas, uno no puede parar, los enfermos no se dejan de enfermar”, destacó el doctor.
tenemos que ser solidarias con esas mujeres, con esas mamás, esas niñas que están hospitalizadas”, subrayó la directora del hospital.
Billie Eilish hace lo que nunca: se quita las capas de ropa y muestra su cuerpo
LA ESCRITORA RECIBIRÁ EL HOMENAJE NACIONAL DE PERIODISMO
Sin embargo, esta convencida de que estas declaraciones no pueden distraerla de su principal propósito que es celebrar su boda: “Claro que sí, yo estoy muy feliz con el próximo evento”, recalcó.
En entrevista para Venga la Alegría de TV Azteca, Gerardo Quiroz reveló que Juan Osorio sí ha tenido varios problemas para respirar; te contamos lo que dijo.
En el Hospital Pediátrico de Legaria, de la alcaldía Miguel Hidalgo, más de 60 por ciento de los 152 trabajadores son mujeres, de ese porcentaje, poco menos de la mitad se ausentó ayer.
La cantante lanzó un video en el que además confronta a la gente que critica su cuerpo
CULTURAL FERNANDO BENÍTEZ EN EL ÚLTIMO DÍA DE ACTIVIDADES DE LA FIL GUADALAJARA 2019.
También es cierto que el paro se resintió en este hospital pediátrico, y debido a ello se tuvieron que tomar medidas extraordinarias para que no se afectara la atención de los menores.
PADRES DE FAMILIA AGRADECIERON AL PERSONAL FEMENINO QUE SÍ ACUDIÓ A TRABAJAR PARA ATENDER A SUS NIÑOS.
Cuarenta años después de haberse iniciado como reportera, hoy Adriana Malvido recibirá el Homenaje Nacional de Periodismo Cultural Fernando Benítez, que se suma a otras distinciones a las que se ha hecho merecedora, entre ellas el premio que también con el nombre de Benítez recibió en 2004 en la FIL de Guadalajara y el Nacional de Periodismo, que le fue otorgado en 2012 en la categoría de entrevista. Autora de libros como Nahui Olin: la mujer del sol y La Reina Roja: el secreto de los mayas en Palenque, Malvido comenzó su carrera en 1979 en el periódico unomásuno, en 1984 participó en la fundación de La Jornada, fue colaboradora de Milenio y actualmente es columnista de El Universal. En entrevista, recuerda al fundador de los suplementos culturales en México y reflexiona sobre el pasado, presente y futuro de un oficio que ha ejercido con disciplina y talento.
Algunas mujeres sí se movieron ayer. Cientos, quizá miles, decidieron apoyar desde su trabajo, como cualquier otro día, la convocatoria que en redes sociales nombraron #UnDíaSinMujeres y #El9NadieSeMueve.
¿Qué significa para ti recibir un premio con el nombre de Fernando Benítez? El nombre de Fernando Benítez es el de un gigante para todos los periodistas culturales. Hablamos del padre de los mejores suplementos culturales del siglo XX, México en la cultura, en el periódico Novedades, La cultura en México en la revista Siempre!, sábado en el unomásuno durante su mejor época y La Jornada Semanal. Hablamos del autor de una obra monumental como Los indios de México. Detonó polémicas y debates de altura en torno a la cultura y el arte, escribió decenas de libros… Cuando lo conocí en el unomásuno en 1979 ya era una leyenda viva. Entonces, recibir un reconocimiento que lleva su nombre es un motivo de felicidad inimaginable, un sueño y un compromiso gigantesco.
Los hospitales de Ciudad de México fueron un ejemplo de ello; una parte del personal femenino se unió al paro de este lunes, pero la mayoría se presentó a laborar a las instituciones de
Esta vez decidió dar un giro total a su exigencia presentando un video en el que, mientras expone su punto de vista, se va quitando la ropa.
Juan Osorio, productor de telenovelas de Televisa, sigue luchando contra el coronavirus, covid-19, tras haber dado positivo. Recientemente se dio a conocer que el ex esposo de Niurka ha tenido que recurrir a una máscara de oxígeno para poder respirar debido a los estragos que le ha dejado este contagio. Te contamos lo que sabemos.
salud.
Como en el Hospital Pediátrico de Legaria, donde mujeres y hombres se vistieron de morado y usaron un moño de ese color para apoyar este movimiento contra la violencia de género.
herramientas tecnológicas?
Esto ocurrió durante el intermedio de uno de los conciertos que ofreció en Miami como parte de su gira Where Do We Go?.
Las áreas donde más se resintió la falta de personal femenino fue en Neonatología y Terapia intensiva, y ya ni hablar en enfermería: la plantilla es de 132 para las 24 horas, 126 son mujeres y seis son hombres. Este lunes llegaron 24 para un turno.
En el clip, que dejó a más de uno con la boca abierta, la cantautora mira a la cámara mientras enfrenta a quienes han criticado su físico.
En entrevista para Venga la Alegría de TV Azteca, Gerardo Quiroz reveló que Juan Osorio sí ha tenido varios problemas para respirar. El ex actor y socio del padre de Emilio Osorio reveló que aunque está estable sí ha tenido que recurrir a una máscara de oxígeno.
“Imagínate que no tuviéramos enfermeras en esos servicios, nuestros pacientes yo creo que fallecerían porque son pacientes graves y el cuidado es integral”, aseguró Lilia Reyes, jefa de Enfermeras del hospital.
“Para suplir la ausencia del personal femenino hemos tenido que pedirle a algunos de nuestros compañeros que doblen su horario de trabajo.
“Nos han preguntado que qué hacemos aquí, que deberíamos estar en nuestras casas; sin embargo, no podemos parar, nuestra función es vital”, exclamó la doctora Angélica Martínez, directora de este hospital.
“Tuvimos una videollamada con él. Pobrecito estaba con su mascarilla, con oxígeno asistido. Sabemos que está delicado pero estable. Estuvo oxigenando mucho mejor”, dijo Gerardo Quiroz en Venga la Alegría.
“¿Te provocan mis hombros? ¿Y mi pecho? ¿Soy yo mi estómago? ¿Mis caderas? El cuerpo con el que nací, ¿no es el que querías? Si llevo lo que me es cómodo, no soy una mujer, Si me quito las capas, soy una pu** y, aunque nunca has visto mi cuerpo, tú lo juzgas y me juzgas a mí por él”, dice Billie Eilish en este controversial video.
¿Qué diferencias encuentras entre el periodismo cultural practicado por Benítez y el que se hace ahora, con la multiplicación de plataformas y
El subdirector Francisco Javier Colin contó que, en cuanto se enteró del paro, la mayoría del personal femenino se acercó a sus superiores para garantizar su presencia en el hospital e incluso ofrecerse a trabajar aunque
“El movimiento es bueno por la violencia que existe en el país, pero el hospital no puede parar, nosotros estamos manifestando el compromiso de ser mujeres pero de una manera pasiva, no provocando más violencia, porque si no me presentara a trabajar yo violentaría los derechos de un menor”, abundó Reyes.
Al final del mismo, la cantante nacida en Los Ángeles de 18 años se queda en brasier como una forma de protesta, pues también pregunta al espectador si le gustaría que fuera más pequeña o más débil, más suave, más alta o más callada. “¿Mi valor se basa sólo en tu percepción o tu opinión sobre mí no es mi responsabilidad?”, se pregunta.
“Es muy fuerte y muy valiente, pero sí lleva tres días con una crisis respiratoria; pero gracias a Dios, a pesar de lo delicado de su salud, está estable. Ha sido muy respetuoso y obediente de lo que le recomendaron los médicos. Está muy bien atendido y eso es muy importante cuando tienes un contagio de covid, atenderte pronto y con especialistas en vías respiratorias y eso es lo que hizo”, comentó.
Con Los indios de México, Benítez se convirtió en una especie de Marco Polo del periodismo mexicano y referencia obligada del periodismo de investigación. Representa el periodismo “de cinco sentidos” del que hablaba Ryszard Kapuscinski, es decir, que ninguna tecnología digital, por más eficiente que sea, puede sustituir la vivencia presencial, el viaje hacia las entrañas de los pueblos indígenas, la entrevista viva en el contexto del otro. Hoy en día, las herramientas tecnológicas nos permiten viajes virtuales, datos que se obtienen con un clic, la inmediatez de la información… pero el periodismo de investigación, el periodismo literario, el que exige amplitud de miras, pasión por el conocimiento y un alto grado de creatividad, ese que ejercía Benítez, nos está haciendo falta. Contamos con herramientas inimaginables para la obtención de datos duros, pero para explorar el alma se requiere mucho más.
“Tenemos vidas a nuestro cargo, tenemos la esperanza de los padres, de las madres que también son mujeres y que
“Yo que habitualmente mi trabajo es de tipo de administrativo, estoy encargado de una sala de medicina interna, tengo que estar revisando pacientes, lo que habitualmente no es lo que hago”, explicó el doctor Colin.
Por ello, algunos padres de familia no quisieron dejar desapercibido el agradecimiento al personal femenino que acudió a trabajar para atender a sus niños.
Hay muy buenos reporteros y periodistas y me impresiona la capacidad de los jóvenes para dominar varias plataformas simultáneamente. Les exigen velocidad por encima de todo. Lo que les hace falta son más tiempo y espacio para realizar reportajes de investigación, entrevistas o crónicas de largo aliento. Pero también lectores que busquen con avidez este tipo de periodismo. Vivimos un desafío muy grande, porque hay un ajuste, un acomodo, en la transición de los medios impresos o analógicos convencionales a las plataformas digitales. El desafío no solo es tecnológico sino económico, porque en este reacomodo las condiciones laborales de los periodistas son cada vez más precarias.
¿Qué cosas echas de menos del periodismo en el que comenzaste tu carrera?
“Nos han dado bendiciones. Desde la mañana nos dijeron: Dios las bendiga por estar aquí”, contó la jefa de enfermeras.
Extraño la redacción, la convivencia con otros reporteros, esas tardes llenas de adrenalina compartida, los licuados que me tomaba cada mediodía con Braulio Peralta (en lugar de comida). La pasión por ganar una nota o una exclusiva. Extraño los debates y polémicas culturales de fondo.
Marlene también trabajó. Llego casi 40 minutos antes a su trabajo, este lunes algo inusual pasó en el transporte público de la ciudad. Ella vive atrás del aeropuerto y la fonda donde trabaja está hacia el sur de la ciudad. La ausencia de mujeres fue visible hasta en el tránsito vehicular.








